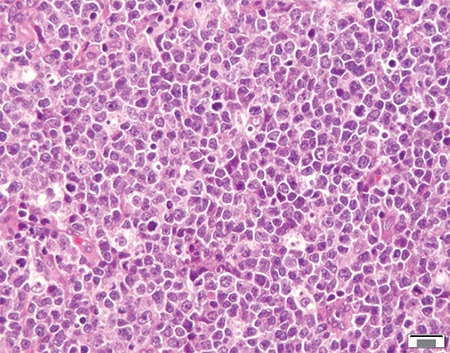

CAP TODAY and the Association for Molecular Pathology have teamed up to bring molecular case reports to CAP TODAY readers. AMP members write the reports using clinical cases from their own practices that show molecular testing’s important role in diagnosis, prognosis, and treatment. The following report comes from UT Southwestern Medical Center. If you would like to submit a case report, please send an email to the AMP at amp@amp.org. For more information about the AMP and all previously published case reports, visit www.amp.org.
Jing Xu, MD, PhD
Abdullah Alsuwaidan, MD
Mingyi Chen, MD, PhD
August 2020—Burkitt-like lymphoma with 11q aberration (BLL-11q) is a new provisional entity in the revised 2016 WHO classification of hematopoietic and lymphoid tumors.1 It refers to a subset of high-grade B-cell lymphomas that resemble Burkitt lymphoma with similar morphology, phenotype, and gene expression profiling, but lack MYC gene rearrangements. Instead, these lymphomas carry chromosome 11q proximal gains and telomeric losses, suggesting co-dysregulation of oncogenes and tumor suppressor genes.
Here, we report a case of Burkitt-like lymphoma with 11q aberration. We contribute to further characterize this rare entity with molecular genomic and clinicopathological features.
Case presentation and history. The patient was a 23-year-old male who presented with rapidly growing nasopharyngeal mass. He denied recent history of fevers, chills, nausea, vomiting, or weight loss. F18-FDG PET/CT scan demonstrated intensely hypermetabolic nasopharyngeal and splenic masses and a left level IIb lymph node. Therefore, the patient underwent nasopharyngeal tissue biopsy.
Results. The H&E sections of the nasopharyngeal mass showed sheets of monomorphic atypical lymphoid infiltrate composed of medium-sized lymphocytes with round nuclei, vesicular chromatin, and inconspicuous nucleoli. Atypical mitotic figures and apoptotic bodies were easily appreciated. Scattered histiocytes in the background rendering starry-sky appearance were noted (Fig. 1). The morphologic features raised the possibility of Burkitt lymphoma or Burkitt-like lymphoma. By immunohistochemistry, the atypical lymphoid infiltrates were diffusely positive for B cell markers (CD20 and PAX-5) with coexpression of CD10 and Bcl-6, and were negative for CD5, Bcl-2, CD30, CD34, c-MYC, EBER, and TdT. The tumor cells showed very high proliferation index with approximately 100 percent of cells positive for Ki-67 (Fig. 2).

Cytogenetic analysis revealed abnormal clone of 48, XY, +X, ?der(11)t(1;11)(q25;q24),+12 (Fig. 3). FISH studies were negative for MYC, BCL2, or BCL6 rearrangements (Fig. 4). To further characterize this tumor, we performed next-generation sequencing using our institutional 1,385-gene panel (gene list at www.utsouthwestern.edu/sites/genomics-molecular-pathology/assets/utsw-informatics-ngs-gene-list-for-web-site-20180807.pdf). NGS confirmed the presence of chromosome 11q gain/loss in the copy number alterations plot (Fig. 5) and detected likely pathogenic hotspot variants in the following genes: EZH2, KMT2D, and ERCC2 (Table 1). No mutations in MYC, FLI1, USP2, CBL, and ETS1 genes were detected. Overall, the combined morphologic, immunohistochemical, and cytogenetic findings were consistent with Burkitt-like lymphoma with 11q aberration.

The patient was then treated with six cycles of dose-adjusted EPOCH (etoposide, cyclophosphamide, doxorubicin, vincristine, prednisone) plus rituximab (DA-EPOCH-R) with prophylactic intrathecal methotrexate. Surveillance PET scan done three months after completing DA-EPOCH-R showed complete remission. The patient is currently doing well with no specific complaints.
Discussion. Burkitt lymphoma is a type of aggressive B-cell lymphoma derived from germinal center B cells. The molecular hallmark of Burkitt lymphoma is the translocation of the MYC gene. It has been controversial whether Burkitt lymphoma without MYC translocation truly exists. The lymphomas with morphological features typical for Burkitt lymphoma but lacking MYC rearrangements were previously classified as atypical Burkitt/Burkitt-like lymphoma.2 Pienkowska-Grela, et al., first reported four MYC-negative Burkitt lymphoma cases with recurrent genetic abnormality within chromosome 11.3 It was then reported that MYC-negative Burkitt lymphoma and Burkitt-like lymphoma carry a peculiar pattern of chromosome 11q aberration characterized by interstitial gains including 11q23.2-q23.3 and telomeric losses of 11q24.1-qter.4 Of note, lymphomas with the typical 11q-gain/loss pattern seem to have more frequent nodal presentation than Burkitt lymphoma, and they are mainly found in children and young adults (younger than 40 years).4 These lymphomas have complex karyotypes compared with Burkitt lymphoma and happen particularly often in post-transplant settings.5,6 These MYC-negative lymphomas were recognized as a new provisional entity, “Burkitt-like lymphoma with 11q aberration,” in the 2016 WHO classification because its precise taxonomy is still controversial.1 A recent study demonstrated that most patients with BLL-11q have favorable treatment outcomes, although optimal clinical management remains to be determined.7

Our case confirms that BLL-11q usually shows complex karyotypes and has lower levels of MYC expression compared with Burkitt lymphoma. The NGS test confirmed the copy number gain of oncogenes PAFAH1B2 and CBL in the q11q23.3 region and the loss of genes ETS1 and FLI1 in the 11q24 region, similar to the previous report.4 The specific features of BLL with 11q aberration raise the question of whether these lymphomas truly belong to the entity of Burkitt lymphoma or should be considered as another set of high-grade B-cell lymphomas with similar features.4

Furthermore, using NGS, we identified additional genomic alterations in this case, including gain-of-function activating mutation in EZH2, loss-of-function frameshift in KMT2D, and splicing site variant in ERCC2. Notably, EZH2 and KMT2D mutations have been reported to be germinal center B cell–specific oncogenic events in lymphomas.8,9 These findings can help us better understand the pathogenesis of this rare entity and identify potential therapeutic targets. For instance, lymphomas harboring EZH2 and KMT2D mutations have been reported to be sensitive to EZH2 inhibitors and HDAC inhibitors, respectively.10,11 With only a limited number of cases reported, further studies are needed to fully understand the significance of these genomic alterations and define the clinical course of this rare entity.

- Swerdlow SH, Campo E, Pileri SA, et al. The 2016 revision of the World Health Organization classification of lymphoid neoplasms. Blood. 2016;127(20):2375–2390.
- Jaffe ES, Harris NL, Stein H, Vardiman JW, eds. WHO Classification of Tumours. Pathology and Genetics of Tumours of Haematopoietic and Lymphoid Tissues. 3rd ed. Vol 3. IARC Press; 2001.
- Pienkowska-Grela B, Rymkiewicz G, Grygalewicz B, et al. Partial trisomy 11, dup(11)(q23q13), as a defect characterizing lymphomas with Burkitt pathomorphology without MYC gene rearrangement. Med Oncol. 2011;28(4):1589–1595.
- Salaverria I, Martin-Guerrero I, Wagener R, et al. A recurrent 11q aberration pattern characterizes a subset of MYC-negative high-grade B-cell lymphomas resembling Burkitt lymphoma. Blood. 2014;123(8):1187–1198.
- Aukema SM, Theil L, Rohde M, et al. Sequential karyotyping in Burkitt lymphoma reveals a linear clonal evolution with increase in karyotype complexity and a high frequency of recurrent secondary aberrations. Br J Haematol. 2015;170(6):814–825.
- Ferreiro JF, Morscio J, Dierickx D, et al. Post-transplant molecularly defined Burkitt lymphomas are frequently MYC-negative and characterized by the 11q-gain/loss pattern. Haematologica. 2015;100(7):e275–e279.
- Gonzalez-Farre B, Ramis-Zaldivar JE, Salmeron-Villalobos J, et al. Burkitt-like lymphoma with 11q aberration: a germinal center-derived lymphoma genetically unrelated to Burkitt lymphoma. Haematologica. 2019;104(9):1822–1829.
- Morin RD, Johnson NA, Severson TM, et al. Somatic mutations altering EZH2 (Tyr641) in follicular and diffuse large B-cell lymphomas of germinal-center origin. Nat Genet. 2010;42(2):181–185.
- Zhang J, Dominguez-Sola D, Hussein S, et al. Disruption of KMT2D perturbs germinal center B cell development and promotes lymphomagenesis. Nat Med. 2015;21(10):1190–1198.
- McCabe MT, Ott HM, Ganji G, et al. EZH2 inhibition as a therapeutic strategy for lymphoma with EZH2-activating mutations. Nature. 2012;492(7427):108–112.
- Højfeldt JW, Agger K, Helin K. Histone lysine demethylases as targets for anticancer therapy. Nat Rev Drug Discov. 2013;12(12):917–930.
Dr. Xu is a resident, Dr. Alsuwaidan was at the time of writing a hematopathology fellow, and Dr. Chen is an associate professor—all in the Department of Pathology, UT Southwestern Medical Center, Dallas. Dr. Alsuwaidan is currently practicing in the Department of Pathology, King Faisal Specialist Hospital and Research Center, Saudi Arabia.
Test yourself
[tabs type=”horizontal”][tabs_head][tab_title]Here are three questions taken from the case report. [/tab_title][tab_title]Answers[/tab_title][/tabs_head][tab]
1. Which of the following statements is true regarding Burkitt-like lymphoma with 11q aberration?
a. It refers to a subset of lymphomas that resemble Burkitt lymphoma but lack MYC translocation.
b. It has a chromosome 11q alteration characterized by proximal gains and telomeric losses.
c. It usually harbors complex karyotype.
d. All of the above
2. What types of cells are Burkitt lymphoma and Burkitt-like lymphoma derived from?
a. Mature B cells of unknown type
b. Pre-germinal center B cells
c. Germinal center B cells
d. Post-germinal center B cells
3. Which of the following ancillary techniques can be used in the diagnosis of Burkitt-like lymphoma with 11q aberration?
a. Fluorescence in situ hybridization (FISH)
b. Array comparative genomic hybridization (aCGH)
c. Next-generation sequencing
d. All of the above
e. None of the above
[/tab]
[tab]
Answers are also online now at www.amp.org/casereports.
1. Which of the following statements is true regarding Burkitt-like lymphoma with 11q aberration?
a. It refers to a subset of lymphomas that resemble Burkitt lymphoma but lack MYC translocation.
b. It has a chromosome 11q alteration characterized by proximal gains and telomeric losses.
c. It usually harbors complex karyotype.
d. All of the above
2. What types of cells are Burkitt lymphoma and Burkitt-like lymphoma derived from?
a. Mature B cells of unknown type
b. Pre-germinal center B cells
c. Germinal center B cells
d. Post-germinal center B cells
3. Which of the following ancillary techniques can be used in the diagnosis of Burkitt-like lymphoma with 11q aberration?
a. Fluorescence in situ hybridization (FISH)
b. Array comparative genomic hybridization (aCGH)
c. Next-generation sequencing
d. All of the above
e. None of the above
[/tab]
[/tabs]